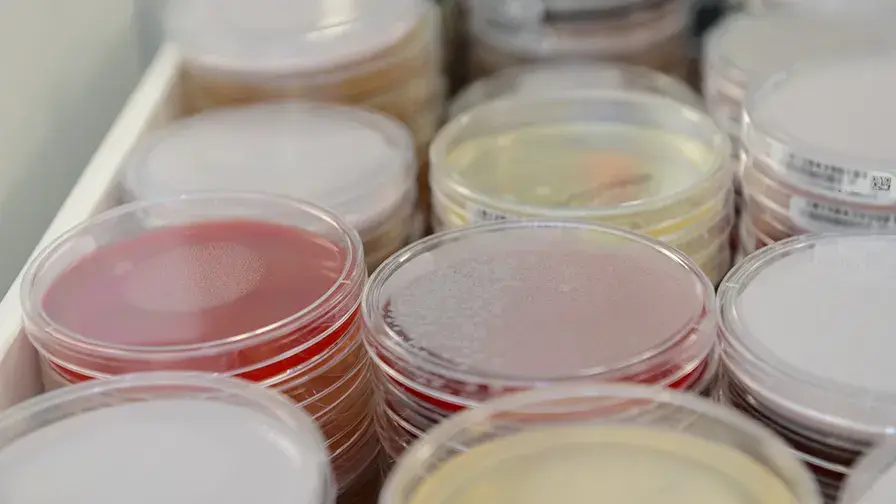
Virus NeuroZika

Mis à jour le 10/02/2025
Les conséquences neurologiques du virus Zika enfin dévoilées
L’infection virale Zika est toujours un problème de santé publique mondial. Son agent pathogène est le virus Zika transmis par les moustiques du genre Aedes. Si le virus est bien connu par les chercheurs et médecins, la fréquence d’apparition des complications neurologiques, leurs tableaux cliniques et leurs pronostics restent encore très énigmatiques. Dans une étude publiée dans Neurology, des équipes de chercheurs français comprenant des équipes de l’hôpital de la Pitié-Salpêtrière AP-HP ont réussi à lever le voile sur les effets à long terme de ce virus.
Afin de rendre compte du spectre complet et du pronostic de neuroZika et d'identifier les facteurs prédictifs de mauvais pronostic, une équipe de chercheurs de l’Institut Pasteur à Paris, en collaboration avec l’Institut Pasteur de Guadeloupe, le Centre hospitalier universitaire de Guadeloupe, le Centre hospitalier universitaire de Martinique, de l’hôpital de la Pitié-Salpêtrière AP-HP l’Institut du Cerveau et de la Moelle épinière, de l’Inserm et du CNRS, a mené une vaste étude d'observation basée sur la population lors de l'épidémie de 2016 aux Antilles françaises.
Ces chercheurs ont étudié tous les malades du Zika qui se sont présentés à l’hôpital et avaient consultés des médecins pour des symptômes neurologiques.
« Les résultats révèlent que le spectre du neuroZika revêt une grande diversité de manifestations cliniques.» souligne Françoise Lazarini, chercheuse au sein de l’Unité de perception et mémoire olfactive dans le département des Neurosciences de l’Institut Pasteur.
Les séquelles à long terme sont donc fréquentes chez NeuroZika et le statut du virus à l'admission du patient peut informer du pronostic. Ces éléments doivent être pris en compte pour adapter le diagnostic et la prise en charge des malades avec neuroZika.
Pour en savoir plus : Lire le communiqué de presse

